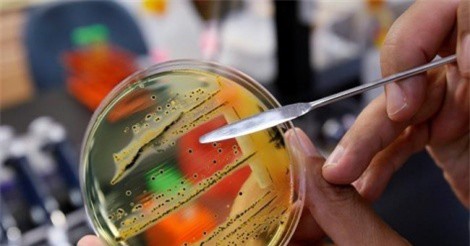
10 bệnh nguy hiểm nhất thế giới được WHO công bố năm 2018

Tìm kiếm: Mers
DNVN - Ngày 10/2, Quỹ Quốc tế Bảo vệ thiên nhiên (WWF) đã kêu gọi đóng cửa các thị trường buôn bán các loài hoang dã trái phép trên toàn châu Á – Thái Bình Dương.
Người nhiễm virus corona thường có triệu chứng ho, sốt, khó thở… nếu không được điều trị có thể bị viêm phổi nặng, suy hô hấp rồi thiệt mạng.
Rắn có thể chính là nguồn gốc của vi rút corona đang gây bệnh viêm phổi đáng lo ngại ở Trung Quốc và bắt đầu lan sang các quốc gia láng giềng.
Đây là thông tin được chia sẻ tại Hội nghị Tăng cường công tác phòng, chống dịch bệnh mùa Đông Xuân và triển khai các nhiệm vụ y tế trọng tâm cuối năm 2019.
Ho, sốt và đau họng là các triệu chứng rõ rệt nhất của cúm. Tuy nhiên, bạn cần phân biệt các dạng cúm khác nhau để điều trị hiệu quả nhất.
Virus Mers đã xuất hiện trở lại tại Hàn Quốc kể từ tháng 7/2015.
Tuy chưa thể đặt tên nhưng mầm bệnh chết người tiếp theo gây ra đại dịch toàn cầu rất có thể là một căn bệnh đường hô hấp, lan tràn bởi một vi-rút lây bệnh trong thời gian ủ bệnh hoặc khi các triệu chứng còn rất nhẹ, theo các nhà nghiên cứu tại Trung tâm An ninh sức khỏe Johns Hopkins.
Ngoài Zika và Ebola, Tổ chức Y tế Thế giới cảnh báo các hội chứng hô hấp sẽ đe dọa sức khỏe toàn cầu trong năm 2018.
(DNVN) - Bộ Y tế vừa công bố 10 sự kiện tiêu biểu nhất của ngành trong năm 2015.
(DNVN)-Một của hàng bán nước tiểu lạc đà ở thành phố Al Qunfudah trên bờ Biển Đỏ, đông nam Ả Rập Xê-út đã phải đóng cửa vĩnh viễn khi bị các nhân viên y tế phát hiện những chai nước tiểu lạc đà thực chất là nước tiểu của chính ông chủ cửa hàng này.
(DNVN) - Hôm 15/9, đại diện Nhà Trắng đã lên tiếng cảnh báo Triều Tiên về chương trình hạt nhân mà nước này đang tiến hành và gọi đây là sự “khiêu khích”.
Mới đây phía ngân hàng trung ương Hàn Quốc (BOK) đã quyết định duy trì lãi suất cơ bản ở mức thấp kỷ lục 1,5%. Quyết định này được đưa ra trong bối cảnh BOK đánh giá ảnh hưởng từ những lần cắt giảm lãi suất gần đây cũng như khả năng Ngân hàng Dự trữ Liên bang Mỹ (FED) lần đầu tiên nâng lãi suất trong gần một thập kỷ.
(DNVN) - Ngân hàng Trung ương Hàn Quốc (BOK) hôm thứ sáu 11/9 tuyên bố sẽ giữ nguyên lãi suất cơ bản ở mức thấp kỷ lục 1,5% tháng thứ ba liên tiếp.
(DNVN) - Mới đây, một tàu đánh cá của Hàn Quốc bị lật đã làm ít nhất 10 người thiệt mạng và nhiều người khác vẫn đang mất tích.
Để ứng phó với những thiệt hại kinh tế mà dịch MERS mới gây ra cho Hàn Quốc. Lượng du khách tới nước này giảm mạnh, ngành du lịch thất thu. Chính vì thế phía Hàn Quốc sắp nâng dịch vụ mua sắm miễn thuế lên một cấp độ hoàn toàn mới, theo đó nước này sẽ đưa giải phẫu thẩm mỹ vào danh sách miễn thuế giá trị gia tăng (VAT) cho du khách nước ngoài. Đây được xem là một trong những chính sách thực tế để lấy lại sức sống cho ngành công nghiệp không khói này.
End of content
Không có tin nào tiếp theo